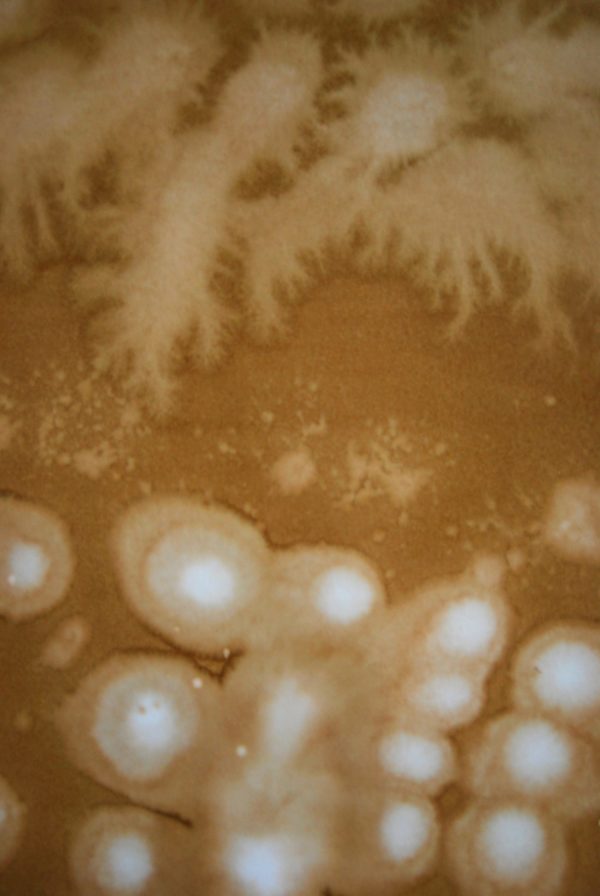

I ALWAYS enjoy abstract water coloring because it takes literally no artistic talent to create gorgeous abstract effects. My brain really responds to color; it brings me joy. Creating these abstractions is nothing but playtime and discovery of happy accidents! In this class we will explore the fun and experimental side of watercolor painting. We will be manipulating watercolors using techniques that will later lend well to texturing traditional watercolor paintings.

- Private class $35 per hour, plus cost of materials (tbd)
- Save money and share costs! Group discounts available! Ask me!
- Classes run 90 minutes for 12 weeks.
- We will learn about various grades and types of paper, the various types of watercolors including liquid, pan, crayons, pens, gouache.
- Techniques covered: Flat wash, graded wash, wet on wet, dry brush, lifting wet and dry, splattering, spray, sgraffito, stamping, backwash, alcohol, salt, tissue paper, plastic wrap, wax resist, blow dryer, straws, tape, bubble wrap, crayon, toothbrush, marbles, string pulling.